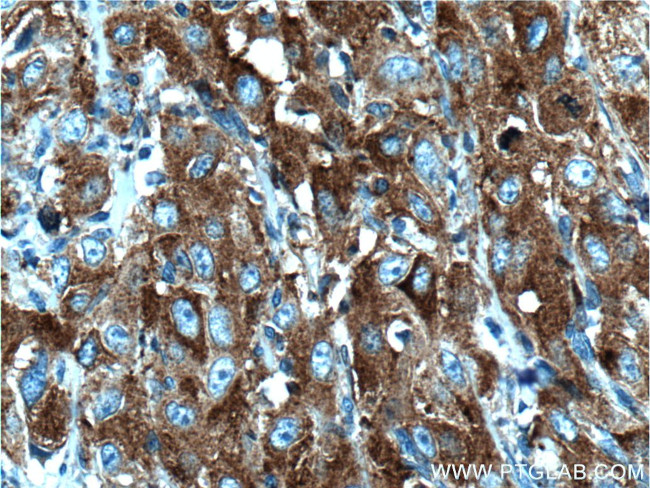
PRPSAP1 Antibody in Immunohistochemistry (Paraffin) (IHC (P))

Search
Proteintech
PRPSAP1 Polyclonal Antibody
{{$productOrderCtrl.translations['antibody.pdp.commerceCard.promotion.promotions']}}
{{$productOrderCtrl.translations['antibody.pdp.commerceCard.promotion.viewpromo']}}
{{$productOrderCtrl.translations['antibody.pdp.commerceCard.promotion.promocode']}}: {{promo.promoCode}} {{promo.promoTitle}} {{promo.promoDescription}}. {{$productOrderCtrl.translations['antibody.pdp.commerceCard.promotion.learnmore']}}
产品信息
16790-1-AP
种属反应
宿主/亚型
分类
类型
抗原
偶联物
形式
浓度
规格
纯化类型
保存液
内含物
保存条件
运输条件
产品详细信息
Immunogen sequence: MNAARTGYR VFSANSTAAC TELAKRITER LGAELGKSVV YQETNGETRV EIKESVRGQD IFIIQTIPRD VNTAVMELLI MAYALKTACA RNIIGVIPYF PYSKQSKMRK RGSIVCKLLA SMLAKAGLTH IITMDLHQKE IQGFFSFPVD NLRASPFLLQ YIQEEIPNYR NAVIVAKSPD AAKRAQSYAE RLRLGLAVIH GEAQCTELDM DDGRHSPPMV KNATVHPGLE LPLMMAKEKP PITVVGDVGG RIAIIVDDII DDVESFVAAA EILKERGAYK IYVMATHGIL SAEAPRLIEE SSVDEVVVTN TVPHEVQKLQ CPKIKTVDIS LILSEAIRRI HNGESMAYLF RNITVDD (1-356 aa encoded by BC009012)
靶标信息
Seems to play a negative regulatory role in 5-phosphoribose 1-diphosphate synthesis. Target protein binds catalytic subunits of the ribose-phosphate diphosphokinase enzyme complex; may act as a negative regulator of enzyme activity.
仅用于科研。不用于诊断过程。未经明确授权不得转售。
篇参考文献 (0)
生物信息学
蛋白别名: 39 kDa phosphoribosypyrophosphate synthase-associated protein; 39 kDa phosphoribosypyrophosphate synthetase-associated protein; kpra; PAP39; Phosphoribosyl pyrophosphate synthase-associated protein 1; phosphoribosylpyrophosphate synthetase-associated protein (39 kDa); PRPP synthase-associated protein 1; PRPP synthetase-associated protein 1; unnamed protein product
基因别名: 5730409F23Rik; PAP39; PRPSAP1
UniProt ID: (Human) Q14558, (Mouse) Q9D0M1
Entrez Gene ID: (Human) 5635, (Mouse) 67763, (Rat) 64390